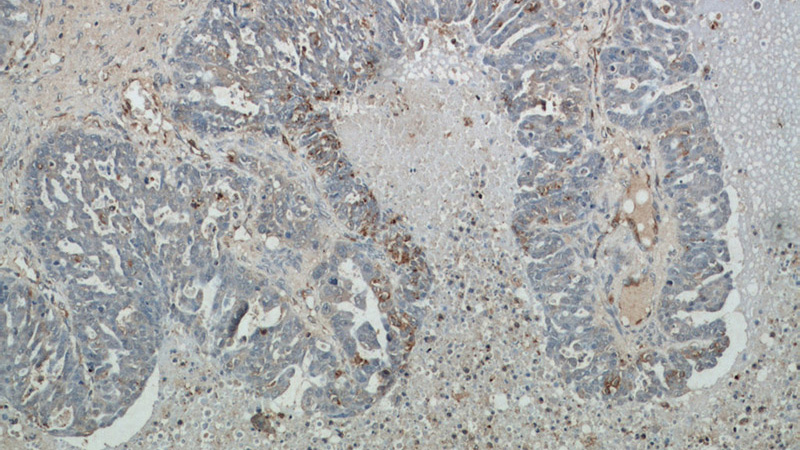
Immunohistochemical of paraffin-embedded human ovary tumor using Catalog No:112807(ABCC5 antibody) at dilution of 1:50 (under 10x lens)
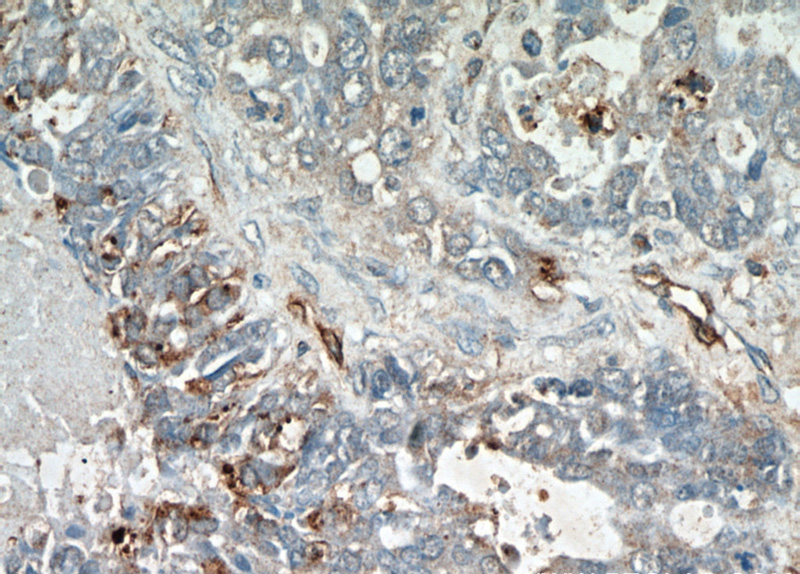
Immunohistochemical of paraffin-embedded human ovary tumor using Catalog No:112807(ABCC5 antibody) at dilution of 1:50 (under 40x lens)

-
Product Name
MRP5 antibody
- Documents
-
Description
MRP5 Rabbit Polyclonal antibody. Positive IHC detected in human ovary tumor tissue, human pancreas cancer tissue.
-
Tested applications
ELISA, IHC
-
Species reactivity
Human,Mouse,Rat; other species not tested.
-
Alternative names
ABC33 antibody; ABCC5 antibody; MOAT C antibody; MOATC antibody; MRP5 antibody; pABC11 antibody; SMRP antibody
-
Isotype
Rabbit IgG
-
Preparation
This antibody was obtained by immunization of Peptide (Accession Number: NM_005688). Purification method: Antigen affinity purified.
-
Clonality
Polyclonal
-
Formulation
PBS with 0.1% sodium azide and 50% glycerol pH 7.3.
-
Storage instructions
Store at -20℃. DO NOT ALIQUOT
-
Applications
Recommended Dilution:
IHC: 1:20-1:200
-
Validations
Immunohistochemical of paraffin-embedded human ovary tumor using Catalog No:112807(ABCC5 antibody) at dilution of 1:50 (under 10x lens)
Immunohistochemical of paraffin-embedded human ovary tumor using Catalog No:112807(ABCC5 antibody) at dilution of 1:50 (under 40x lens)
-
Background
ABCC5, also named as MOAT-C, pABC11, SMRP and MRP5, belongs to the ABC transporter superfamily, ABCC family and Conjugate transporter (TC 3.A.1.208) subfamily. ABCC5 acts as a multispecific organic anion pump which can transport nucleotide analogs. ABCC5 functions in the cellular export of its substrate, cyclic nucleotides. This export contributes to the degradation of phosphodiesterases and possibly an elimination pathway for cyclic nucleotides. Studies show that ABCC5 provides resistance to thiopurine anticancer drugs, 6-mercatopurine and thioguanine, and the anti-HIV drug 9-(2-phosphonylmethoxyethyl) adenine. ABCC5 may be involved in resistance to thiopurines in acute lymphoblastic leukemia and antiretroviral nucleoside analogs in HIV-infected patients. Alternative splicing of this gene has been detected; however, the complete sequence and translation initiation site is unclear.
Related Products / Services
Please note: All products are "FOR RESEARCH USE ONLY AND ARE NOT INTENDED FOR DIAGNOSTIC OR THERAPEUTIC USE"
